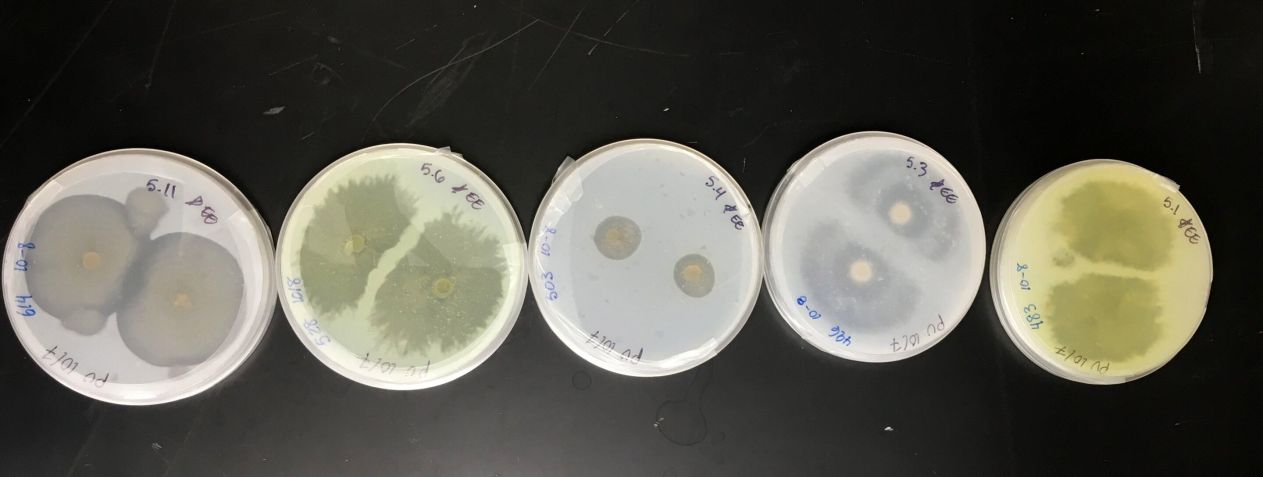
Fungos marinhos isolados de O'ahu comendo plástico de poliuretano • Ronja Steinbach, Universidade do Havaí

Fungos marinhos podem ser treinados para comer plásticos dos oceanos
Organismos coletados do mar e separados em laboratório podem decompor materiais plásticos e serem condicionados a aumentar eficiência na degradação

De todos os tipos de poluição marinha, o plástico é, hoje, o mais comum e abundante. Sua predominância nos oceanos é tão grande que esses polímeros resistentes estão se transformando em um novo tipo de habitat.
Isso significa que, além de poluir, os detritos plásticos estão criando um novo ecossistema artificial, que vem sendo aos poucos colonizado por diversas formas de vida marinha, subvertendo os habitats naturais.
Os resultados podem ser devastadores para os ecossistemas oceânicos, como a dispersão das espécies (a bordo de detritos plásticos flutuantes), impactos na cadeia alimentar, alterações químicas e tóxicas, além de mudanças imprevisíveis na biodiversidade local.
Um estudo publicado na revista Mycology propõe uma solução biológica natural para o problema da poluição plástica nos oceanos: fungos isolados do ambiente costeiro do Havaí, capazes de degradar o plástico e serem treinados para fazer isso em um tempo mais rápido.
Em um comunicado, a primeira autora do artigo, Ronja Steinbach, graduanda da Universidade do Havaí em Mānoa, explica: “Nossa pesquisa destaca os fungos marinhos como um grupo promissor e amplamente inexplorado para investigar novas maneiras de reciclar e remover o plástico da natureza”.
Fungos marinhos podem ser parte da solução do problema dos plásticos

Embora muitos fungos terrestres já tenham sido pesquisados ao degradar diversos tipos de plástico, a equipe da UH Mānoa decidiu apostar na grande coleção de fungos disponíveis em suas belas praias, e começaram a isolá-los de areia, algas marinhas, corais e esponjas.
“Muito poucas pessoas estudam fungos no oceano, e estimamos que menos de um por cento dos fungos marinhos são descritos atualmente", afirma Steinbach, justificando a escolha desse grupo funcional ecológico como promissor (e ainda inexplorado) para investigar novas formas de reciclagem.
Para o líder da pesquisa, Anthony Amend, do Pacific Biosciences Research Center, há ainda outro bom motivo: “Os fungos possuem um superpoder para comer coisas que outros organismos não conseguem digerir (como madeira ou quitina)”.
Por isso, ele, juntamente com Steinbach e a outra coautora Syrena Whitner, decidiram testar os fungos isolados em seu laboratório, quanto à sua capacidade de comer plástico.
Destacando a faculdade perversa de se decompor em pedaços menores (microplásticos), capazes de entrar em nosso suprimento de comida e água potável, os autores reconhecem que a solução do problema do plástico não acontecerá da noite para o dia, mas acreditam que o fungo pode ser parte da solução.
Testando a capacidade dos fungos em digerir plásticos
Para testar suas hipóteses, os autores realizaram ensaios de degradação visual, no qual 68 cepas diferentes de fungos cultivadas em habitats marinhos foram inoculadas em um meio contendo 1% de poliuretano (PU), um tipo comum de plástico.
Os fungos selecionados foram expostos pela equipe a pequenos pratos (placas de Petri) cheios de PU, para observar se eles seriam capazes de consumir o plástico, e com que rapidez o fariam.
Em seguida, pegaram os fungos que cresceram mais rápido e os “evoluíram experimentalmente”, para conferir se, mais expostos ao poliuretano, “poderiam se adaptar para comer plástico de forma mais rápida e eficiente”, diz o comunicado.
Para Steinbach, o resultado foi surpreendente: "Ficamos chocados ao descobrir que mais de 60% dos fungos que coletamos do oceano tinham alguma capacidade de comer plástico e transformá-lo em fungos".
Mas o que mais impressionou foi a sua capacidade de adaptação: em um período de apenas três meses, “alguns dos fungos foram capazes de aumentar suas taxas de alimentação em até 15%”, concluiu a pesquisadora.
Os resultados foram tão satisfatórios, que a equipe prepara agora seus fungos para testes de decomposição de outros tipos de plásticos, como polietileno e tereftalato de polietileno. Eles também querem entender como essa degradação acontece em nível molecular.
No comunicado à imprensa, Steinbach diz que a expectativa dos autores é "colaborar com engenheiros, químicos e oceanógrafos que possam aproveitar essas descobertas em soluções reais para limpar nossas praias e oceanos", conclui.



